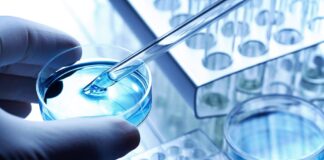
شرکتهایی که وارد حوزه تولید داروی بیماریهای نادر شوند، کمک بزرگی به بیماران میکنند

صدا کن مرا صدای تو خوب است… رسانه تخصصی «دنیای سلامت و دارو» یک سایت و پایگاه تحلیلی/ خبری در دو حوزه صنعت «دارو» و «غذا» است. این یک رسانهی با انگیزه برای خدمت به زیست سالم مردم است. ما برای تعالی دو صنعت بزرگ غذا و دارو و بانیان آن و بهویژه داروسازان شریف؛ آنان که میکوشند با امیدواری؛ زندگی بدون ملامت برای مردم کشور عزیزمان ایران رقم بزنند، فعال هستیم. این سایت کار خود را از خرداد ۱۴۰۰ آغاز کرده و با بهکارگیری تحریریهای حرفهای، در دو درگاه دیگر رسانهای؛ کانال تلگرامی و صفحه اینستاگرامی هم فعال است.«دنیای سلامت و دارو» رسانهی مطمئن صنعت
تمام حقوق این سایت متعلق به اخبار دنیای سلامت و دارو می باشد - طراحی و سئو :امید اسمعیلی